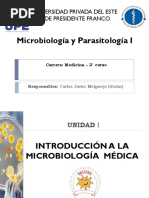

SECCIN I
BASES DE LA
MICROBIOLOGA
Captulo 1
La ciencia de la
microbiologa
�QUE ES MICROBIOLOGA?
�SECCIN I. BASES DE LA MICROBIOLOGA
Captulo 1. La ciencia de la microbiologa
Microbiologa: Ciencia que estudia
los microorganismos microscpicos
Realizan fotosntesis
Todos los derechos reservados.
McGraw-Hill Interamericana Editores
Son los encargados de los ciclos de los
elementos qumicos
Constituyen el 90% de la
biomasa
90% de las clulas humanas
�SECCIN I. BASES DE LA MICROBIOLOGA
Captulo 1. La ciencia de la microbiologa
Todos los derechos reservados.
McGraw-Hill Interamericana Editores
Microbiologa:
Utiliza el
Mtodo
cientfico?
�SECCIN I. BASES DE LA MICROBIOLOGA
Todos los derechos reservados.
McGraw-Hill Interamericana Editores
Captulo 1. La ciencia de la microbiologa
Microorganis
mos
Son
producto
de la
evolucin
Consecuencia
de
la seleccin
natural
�SECCIN I. BASES DE LA MICROBIOLOGA
Todos los derechos reservados.
McGraw-Hill Interamericana Editores
Captulo 1. La ciencia de la microbiologa
�SECCIN I. BASES DE LA MICROBIOLOGA
Todos los derechos reservados.
McGraw-Hill Interamericana Editores
Captulo 1. La ciencia de la microbiologa
� Son agentes infecciosos ms pequeos.
Contiene un solo tipo de cido nucleico.
La unidad infecciosa se denomina virion.
Son inertes al entorno extracelular.
Se replican solo en clulas vivas donde actan
como parsitos a nivel gentico.
La infeccin viral puede tener poco o ningn
efecto o es posible que cause dao o la muerte .
Generalidade
�Orgenes
Evolutivos
Dos teoras:
1. Los virus pueden derivarse de
componentes de cidos nucleicos
de DNA o RNA de clulas
hospedadoras que adquieren la
capacidad de replicarse.
2. Los virus pueden ser formas
degeneradas de parsitos
intracelulares.
�VIRUS
Carecen de capacidad
de multiplicarse por si
mismos
Solo cuando infectan
una clula se pueden
reproducir
La partcula viral
contienen ADN y ARN
Cubierta por una
cpside
( proteccin)
�VIROIDES
PEQUEAS MOLCULAS DE RNA TRANSMITEN
ENFERMEDADES EN LAS PLANTAS
LAS MOLECULAS DE RNA NO
CONTIENEN GENES QUE
CODIFIQUEN PROTEINAS POR LO
TANTO DEPENDEN DEL
HOSPEDADOR PARA
MULTIPLICARSE
SE MULTIPLICA POR MEDIO DEL
RNA POLIMERASA
(PATOGENICIDAD DEL VORIOIDE)
�PRIONES :
PROTEINA INFECCIOSA
CAUSANTE
ENFERMEDADES
DEGENERATIVAS
EL TRMINO PRION
SEALA SU
NATURALEZA
PROTEINICA E
INFECCIOSA
EN LOS HUMANOS SE
MANIFIESTAN COMO
ENFERMEDADES
ESPORADICAS
�PRIONES :
La forma celular de la protena
prinica(PrPc) es codificada por el
DNA cromosmico del hospedador.
La PrPc es una sialoglucoprotena
con un peso molecular de 33 000 a
35 000 y un alto contenido de una
estructura helicoidal secundaria
que es sensible a las proteasas y
soluble en detergente.
�Todos los derechos reservados.
McGraw-Hill Interamericana Editores
PRIONES
Resistentes a
la activacin
por calor,
formaldehido,
y luz
ultravioleta.
SECCIN I. BASES DE LA MICROBIOLOGA
Enfermedade
s
encefalopata
s
espongiforme
s
transmisibles
Captulo 1. La ciencia de la microbiologa
Tembladera
de ovejas,
enfermedad
de las vacas
locas y
enfermedad
de
creutzfeldtJakob.
�SECCIN I. BASES DE LA MICROBIOLOGA
Todos los derechos reservados.
McGraw-Hill Interamericana Editores
Captulo 1. La ciencia de la microbiologa
Figura 1-1 Prin. Priones
aislados a partir del cerebro de un
hmster infectado con el agente
de la encefalopata espongiforme
ovina. Esta enfermedad
neurodegenerativa es causada por
un prin. (Reimpresa con
autorizacin de Stanley B.
Prusiner.)
�SECCIN I. BASES DE LA MICROBIOLOGA
Todos los derechos reservados.
McGraw-Hill Interamericana Editores
Captulo 1. La ciencia de la microbiologa
�SECCIN I. BASES DE LA MICROBIOLOGA
Captulo 1. La ciencia de la microbiologa
Virus
Todos los derechos reservados.
McGraw-Hill Interamericana Editores
Cuadro 1.2
Caractersticas distintivas de los virus , viroides
y priones
Viroides
Priones
Microorganismos
intracelular
obligados
Microorganismos
intracelular
obligados
Forma anormal de
una protena
celular
Consta de DNA o
RNA rodeado por
una cpside
Consta
nicamente de
RNA , no tiene
cpside
Consta
nicamente de
protenas ; sin DNA
no RNA
�SECCIN I. BASES DE LA MICROBIOLOGA
Todos los derechos reservados.
McGraw-Hill Interamericana Editores
Captulo 1. La ciencia de la microbiologa
Figura 1-2 Mecanismo
propuesto por medio del
cual se replican los priones.
Las protenas normales y
anormales del prin
difieren en su estructura
terciaria. (Reimpresa con
autorizacin de Nester EW,
Anderson DG, Roberts CE,
Nester MR (editores):
Microbiology: A Human
Perspective, 6th ed.
McGraw-Hill, 2009, p. 342.)
�TIPOS DE CLULAS
EUCARIOTAS : contienen un ncleo
rodeado por una membrana,
tamao relativamente garande y
organelos citoplasmaticos
PROCARIOTAS : el DNA no se
separa del citoplasma
�Cinco Reinos
Animalia
monera
Protista
Plantae
Fungi
�CLASIFICACIN
PROTISTA :
EUCARIOTAS
MONERA :
PROCARIOTA
S
�COMUNIDADES
PROCARIOTAS
Consorcio : organizaciones en
donde las caractersticas
fisiolgicas de los diferentes
microorganismos contribuyen a la
supervivencia del grupo.
Clon :todos los microorganismos
se derivan directamente de una
clula dentro del cromosoma
( asegura el proceso evolutivo y
la proteccin especialmente
contra antibiticos).
�SECCIN I. BASES DE LA MICROBIOLOGA
Todos los derechos reservados.
McGraw-Hill Interamericana Editores
Captulo 1. La ciencia de la microbiologa
�CLASIFICACIN DE LAS BACTERIAS
Algunos criterios NO son
Adecuados:
La posesin de ADN (todos los
m.o. lo contienen)
La presencia de un plsmido :
existen en distintos hospederos
pero no es necesario que existan
todo el tiempo
�PLASMIDOS
ELEMENTOS PEQUEOS Y ESPECIALIZADOS
QUE SE PUEDEN MULTIPLICAR AL MENOS
EN UNA LINEA CELULAR PROCARIOTA
SE TRANSFIEREN DE UNA CELULA A OTRA
EXHIBEN UN AMPLIO ESPECTRO DE
HOSPEDEROS
PLASMIDOS DE RESISTENCIA A LOS
FARMACOS
�CLASIFICACIN DE LAS BACTERIAS
Algunos criterios SI son Adecuados:
La posesin esporas : estructuras
especializadas para sobrevivir en
ambientes extremos
Tincin de Gram : la respuesta al
colorante refleja diferencias de la
superficie bacteriana, divide en dos
grupos Gram Positivas y Gram
Negativas
�TIPOS DE CLULAS
EUCARIOTAS
PROCARIOTA
S
�SECCIN I. BASES DE LA MICROBIOLOGA
Captulo 1. La ciencia de la microbiologa
Todos los derechos reservados.
McGraw-Hill Interamericana Editores
TIPOS DE CLULAS
�SECCIN I. BASES DE LA MICROBIOLOGA
Todos los derechos reservados.
McGraw-Hill Interamericana Editores
Captulo 1. La ciencia de la microbiologa